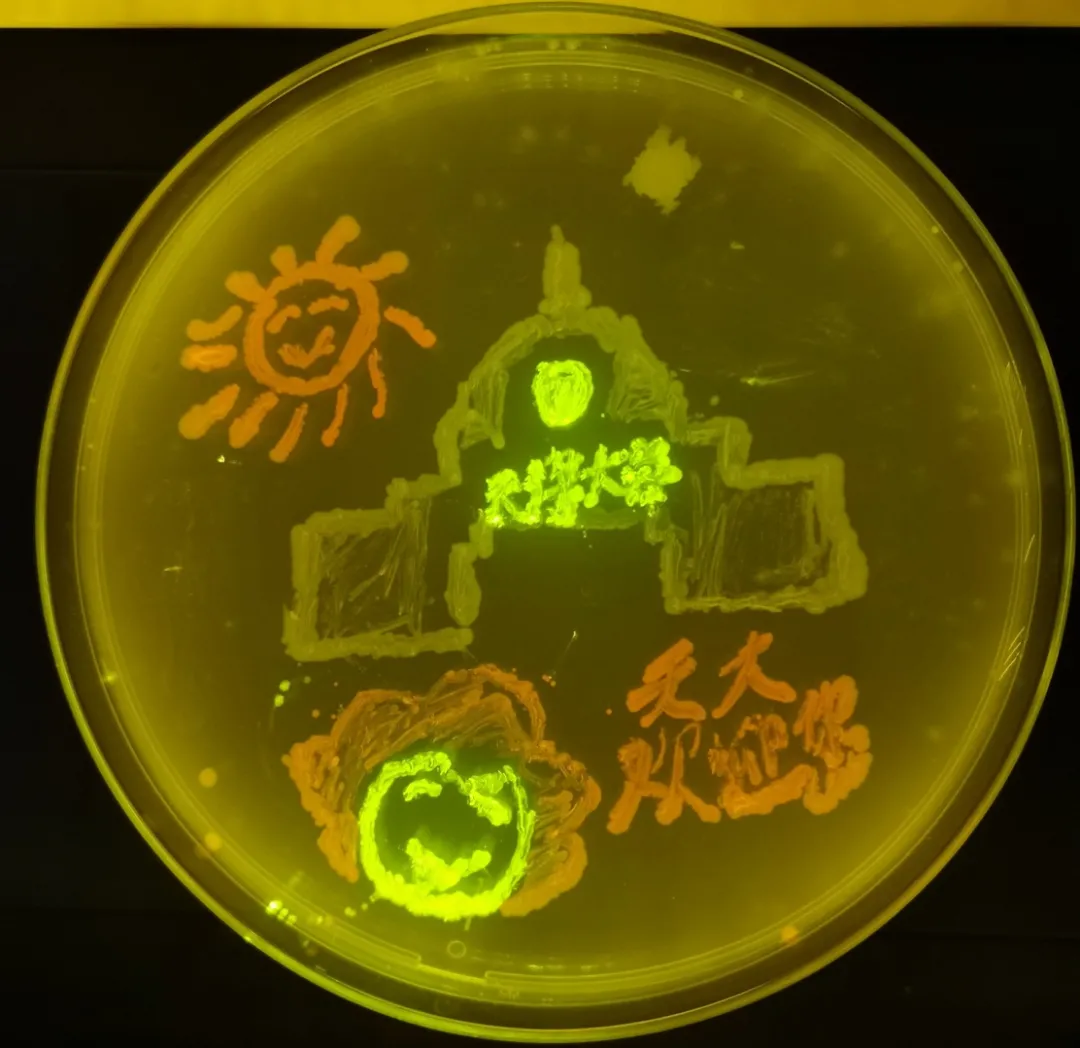
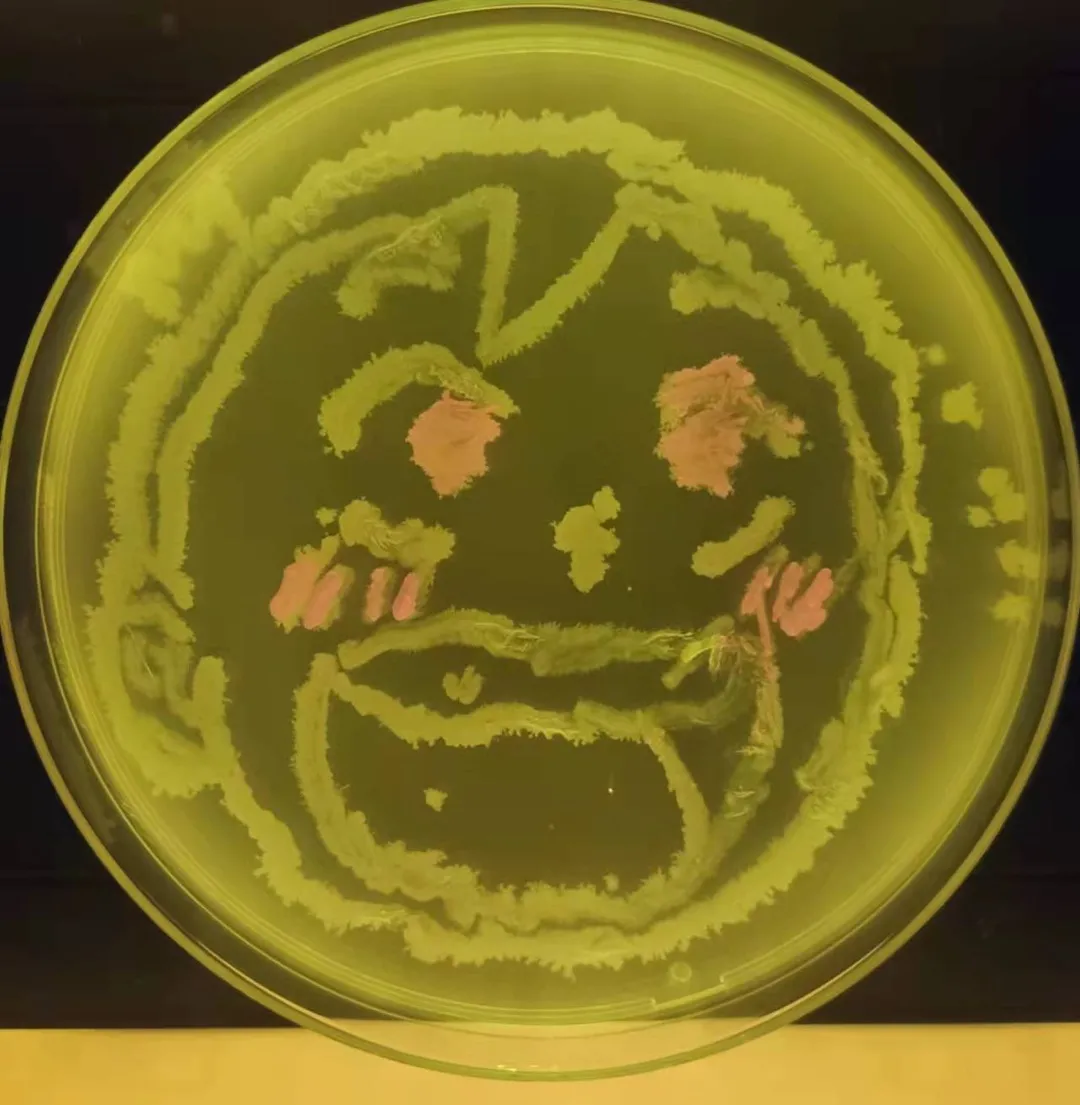

没有圈范围,没有划重点,天津大学化工学院2019级生物工程专业的同学们完成了本学期“微生物学实验课”的期末考试的部分内容。
微生物学实验课是天津大学化工学院针对生物工程、制药工程和合成生物学三个专业的百余名大三学生开设的一门课程。通过这门课,同学们要掌握微生物分离、培养等无菌操作技术,同时还要认知细菌、霉菌、放线菌、酵母菌等十余种微生物的典型形态和生长特性。期末考试中,为了让同学们既掌握课内所学知识,又让考试变得更有趣,授课老师王智文副教授和授课组的冯远航及朱勇老师今年尝试了将微生物绘画作为考试内容之一,其他的两项考试为显微摄影和革兰氏染色。

于是,就有了学生们以培养皿为画布,以微生物为颜料,在培养皿上创作的这一幅幅匠心独运、画风精美的微生物画。完成一幅微生物画,需要同学们在燃烧的酒精灯创造的一定无菌环境下,用培养皿、接种环或微量移液器吸头和微生物分别充当“画布”“画笔”和“颜料”作画。



老师们惊喜地发现,很多同学选择了以冬奥会、建党百年、科学家、抗疫等为题材进行创作。同学们完成画作时的认真和较劲,甚至反复作画以求画作更精美,也让老师们颇有感触。“用霉菌画雪,既形象又有意境。你看这一幅幅画,将科学之美与艺术之美相结合,又与当下青年大学生关注的热点相结合,对这些理工科的学生来说,这样的期末考试也是一堂生动的思政课。”王智文一边展示同学们的作品一边感慨地说。
事实上,王智文还在尝试将课题组科研成果引入本科生课程,如让同学们重复课题组实验成果,以构建的发出红色,暗红色,黄色和绿色的细菌作为染料供同学们作画使用,让微生物画作的色彩更丰富。
(光明日报全媒体记者刘茜 陈建强 通讯员 刘晓艳 图片由王智文、全莉提供)
光明日报:https://mp.weixin.qq.com/s/XPQjl4XIT1gN5zH2kS1swQ
(编辑 赵晖 王昊恩)